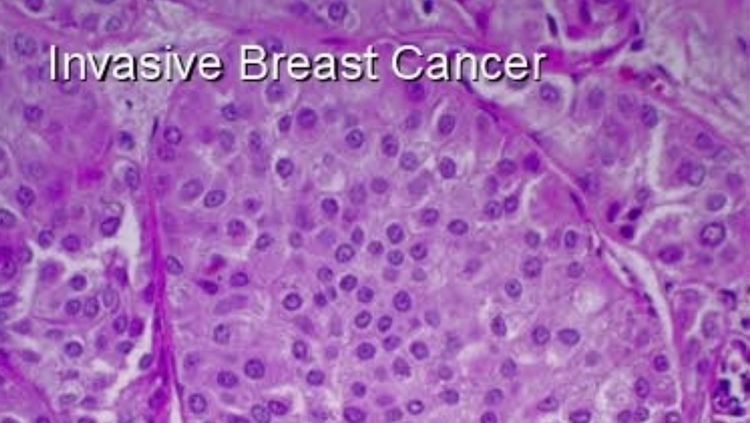

कॅन्सर हा शब्द भल्याभल्यांना धडकी भरवणारा. कॅन्सर म्हणजे मरण, कॅन्सर म्हणजे सगळं काही कॅन्सलच! अशीच त्याची ख्याती आहे. पण म्हणून हे शब्दशः खरं नाही. खरंतर आपलं शरीर हा एक मोठा चमत्कार आहे. दररोज आपल्या शरीरातल्या पेशी कॅन्सर पेशी होण्याकडे वाटचाल करत असतात, पण शरीर मात्र बरोब्बर त्यावर नियंत्रण ठेवू पाहतं. त्यासाठी शरीराकडे सुसज्ज यंत्रणा असते. एखादी पेशी कॅन्सर पेशी बनण्याच्या दिशेने जात आहे हे शरीराला कळलं, की ताबडतोब या यंत्रणेच्या माध्यमातून तिला थांबवण्याचा, तिने 'न ऐकल्यास'(!) तिला नष्ट करण्याचा प्रयत्न केला जातो. त्यामुळे नैसर्गिकरित्या शरीराकडूनच कॅन्सर होऊ न देण्यासाठी प्रयत्न केले जातात.
साध्या रक्तचाचणीतून ब्रेस्ट कॅन्सरचं निदान!! नाशिकच्या लॅबच्या संशोधनाला आंतरराष्ट्रीय मान्यता मिळालीय!


पण म्हणून हेही नेहमीच होत नाही. एखादं व्रात्य मूल जसं आईच्या सांगण्याला न जुमानता खेळायला म्हणून हळूच घराबाहेर निसटतं, तसं एखादी पेशीही या प्रतिकारयंत्रणेच्या तावडीतून निसटते. सगळे अडथळे पार करत बेफाम सुटते. आपल्या असंख्य आवृत्त्या काढते. जेव्हा अशा प्रकारे पेशींचं अनियंत्रित विभाजन सुरू होतं तेव्हा ट्युमर तयार होतो. कॅन्सरचा प्रादुर्भाव होतो तो अशा प्रकारे.
एक मात्र आहे. दुर्धर असला तरी कॅन्सर पूर्णतः नियंत्रणापलीकडे गेलेला विकार नाही. उलट वेळेत निदान झाल्यास तो पूर्णपणे बरा होऊ शकतो. अर्थात हेही म्हणणं पूर्ण सत्य नाही. कित्येकदा वेळेत निदान होऊनदेखील मृत्यू टळत नाही, तर अनेकदा डॉक्टरांनी हात टेकल्यावरही रुग्ण आश्चर्यकारकरित्या बरा होतो. पण तरी लवकर निदान झाल्याने रुग्ण वाचण्याची शक्यता वाढते हे खरं आहे.

याच विधानाला पुष्टी देणारी एक घटना नुकतीच घडली आहे. कॅन्सरच्या, प्रामुख्याने ब्रेस्ट कॅन्सरच्या, विकाराने ग्रस्त असलेल्या किंवा हा विकार होण्याचा धोका असलेल्या सर्व स्त्रियांसाठी ही घटना म्हणजे एक प्रकारे गुड न्यूज आहे. आता धोकादायक गटातल्या स्त्रिया कोण? तर आनुवंशिकता, हॉर्मोनल थेरपी, उशिरा मूल होणं किंवा मूल न होणं यांसह अनेक कारणांमुळे ज्यांना हा विकार होण्याचा धोका जास्त आहे अशा सर्व स्त्रिया. अशा सगळ्यांसाठी नासिकच्या दातार लॅब या प्रयोगशाळेने ब्रेस्ट कॅन्सरचं वेळेत निदान करणारी रक्त चाचणी विकसित केली आहे आणि तिला अमेरिकेच्या यूएस एफडीएने (युनायटेड स्टेट्स फूड अँड ड्रग ऍडमिनिस्ट्रेशन) मान्यता दिली आहे. या लॅबला यूएस एफडीएकडून 'ब्रेक थ्रू डेसिग्नेशन स्टेटस' मिळालं आहे. अत्यंत गंभीर आणि दुर्धर विकारांवर प्रभावी उपचारपद्धती किंवा औषध विकसित करण्यासाठी हे स्टेटस एफडीएकडून दिलं जातं.

या रक्तचाचणीच्या आधारे ब्रेस्ट कॅन्सर या विकाराशी संबंधित ट्युमरच्या पेशी आणि क्लस्टर अचूकपणे शोधता येणं शक्य होणार आहे. दातार लॅबच्या म्हणण्यानुसार, क्लिनिकल ट्रायल्समधून मिळालेल्या माहितीनुसार या चाचणीची अचूकता ९९% आहे आणि स्टेज झिरो आणि स्टेज वन ब्रेस्ट कॅन्सरचं निदान करण्यासाठी ती वापरता येऊ शकते. स्टेज झिरो ब्रेस्ट कॅन्सरमध्ये कॅन्सरपेशी केवळ स्तनांमध्ये असणाऱ्या दुग्ध ग्रंथींमध्ये असतात आणि त्या इतरत्र पसरलेल्या नसतात. स्टेज वन ब्रेस्ट कॅन्सरमध्ये कॅन्सरपेशी आकाराने लहान असल्या तरी आजूबाजूच्या ऊतींमध्ये त्यांचा शिरकाव झालेला असतो. शिवाय यामध्ये चुकीने पॉझिटिव्ह निदान होण्याची शक्यता कमीत कमी आहे. आत्तापर्यंत निरोगी आणि कॅन्सरग्रस्त अशा दोन्ही प्रकारच्या २०,००० पेक्षा जास्त स्त्रियांवर ही चाचणी करण्यात आली आहे. त्यासाठी फक्त पाच मिलीलीटर रक्त काढून घेतलं जातं. शिवाय मॅमोग्राफीसारखा रेडिएशनशी संबंधही नाही.

पण रक्त चाचणीतून हे निदान कसं करता येतं?
तर त्यासाठी ब्लड मार्कर ही संकल्पना समजून घ्यायला हवी. कॅन्सरचे ट्यूमर्स विशिष्ट प्रकारची प्रथिनं तयार करून रक्तात सोडतात. या प्रथिनांना ब्लड मार्कर्स म्हणतात. ही प्रथिनं आणि रक्तात फिरणाऱ्या ट्युमरच्या पेशी या रक्त चाचणीद्वारे ओळखता येतात. त्यावरून कॅन्सरचं निदान करता येतं.
आज भारतामध्ये दीड लाखांपेक्षा जास्त महिला या विकाराने ग्रस्त आहेत. त्यातील बहुतेकजणी स्टेज थ्री किंवा फोरपर्यंत गेलेल्या आहेत. अशा रुग्णांना उपचार म्हणून दिली जाणारी औषधं ही अतितीव्र आणि अनेक साइड इफेक्ट्स असणारी असतात. एवढं करूनही रुग्ण वाचण्याची शक्यता कमीच असते. पण वेळेत निदान झाल्याने ९९% महिलांच्या बाबतीत हा कॅन्सर बरा होऊ शकतो. या दिशेने एक पाऊल पडलंय हे नक्की.

तुलनेने कमी वेळात होणारी आणि करायला सोपी अशी ही चाचणी अनेक महिलांसाठी वरदान ठरेल, असा लॅबच्या प्रवर्तकांना विश्वास आहे. 'इझी चेक' या नावाने ओळखली जाणारी ही चाचणी काही दिवसातच भारतात वाजवी किमतीत सर्वत्र उपलब्ध होईल. याशिवाय ही लॅब फुफ्फुस, स्वादुपिंड आणि अंडाशयाच्या कर्करोगाचं निदान करणारी चाचणीही विकसित करत आहे. पुढच्या वर्षी ती उपलब्ध होईल.
या चाचणीमुळे कॅन्सरविरोधी लढ्यात आपण एक महत्त्वाचा विजय मिळवला आहे, असं मानायला हरकत नाही.
स्मिता जोगळेकर